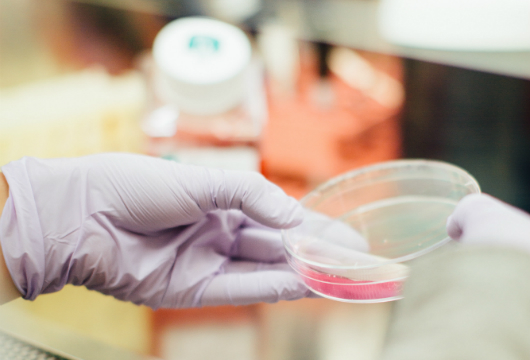

The Problem Solver
Enjoys analyzing and solving problems. Prefers observing, thinking and understanding information. Likes to work with DATA.
Careers
Construction & Skilled Trades
Construction & Skilled Trades
Related Spotlights

Selena Castro gives college advice for high school students.

Selena Castro gives advice for high school students.

Selena Castro gives interview advice for students.

Selena Castro gives advice for First Generation students.

Gladeo reporter, Katelyn Torres interviews Selena about her job as Senior Director of Partnership at EdLight.

Gladeo League reporter Katelyn Torres interviews Jessica about her job as console operator and shift leader at Shell Oil Martinez.